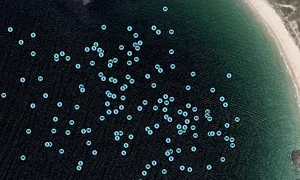

LES LOUSTIKS, MMSI: 227803440
 France
France
Follow the journey
Images of LES LOUSTIKS
Journey statistics
Preferred harbour type
2026
67% marina
natural harbour 33%
2025
33% marina
natural harbour 67%
2024
80% marina
natural harbour 20%
2023
60% marina
natural harbour 40%